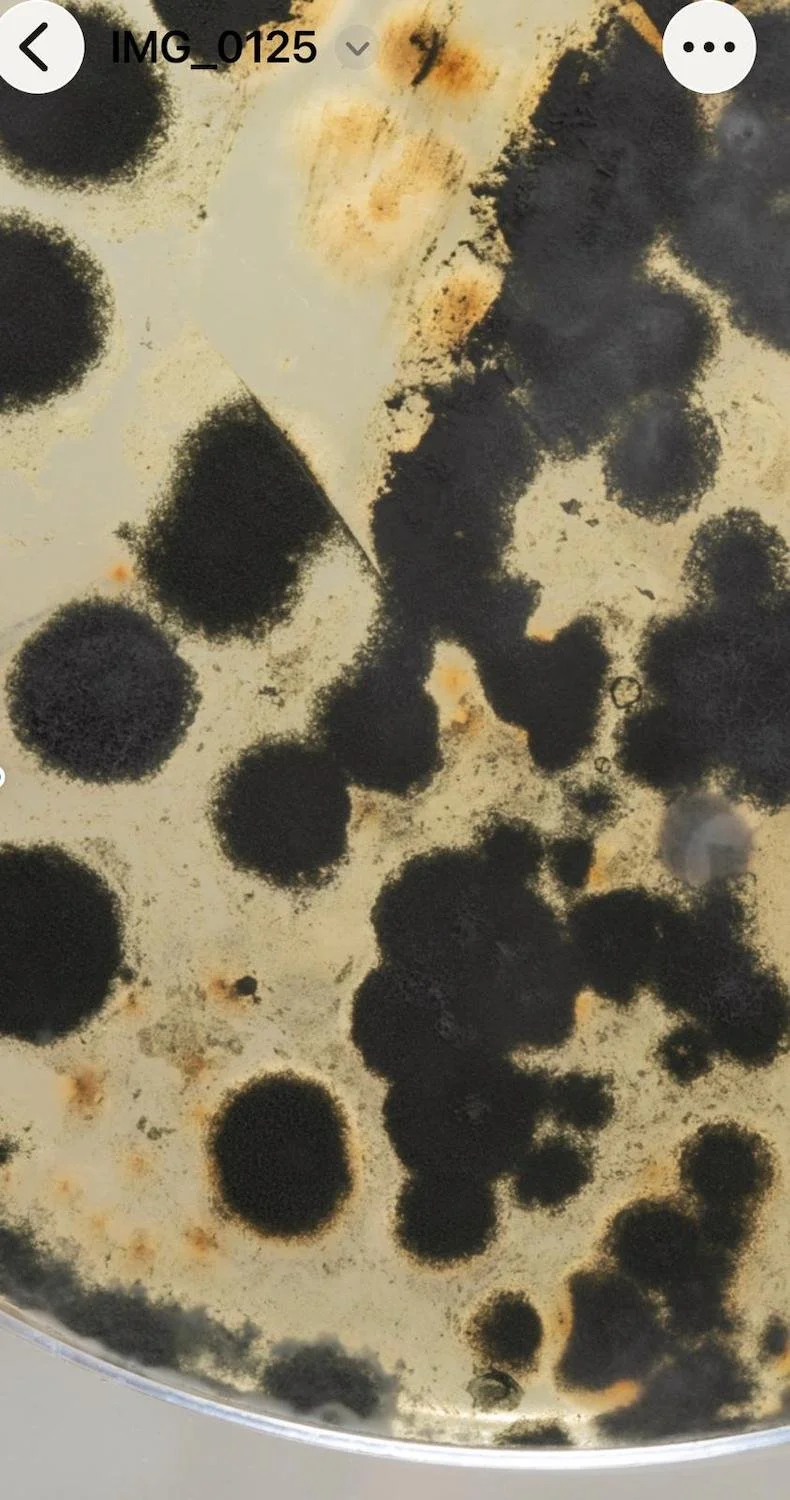
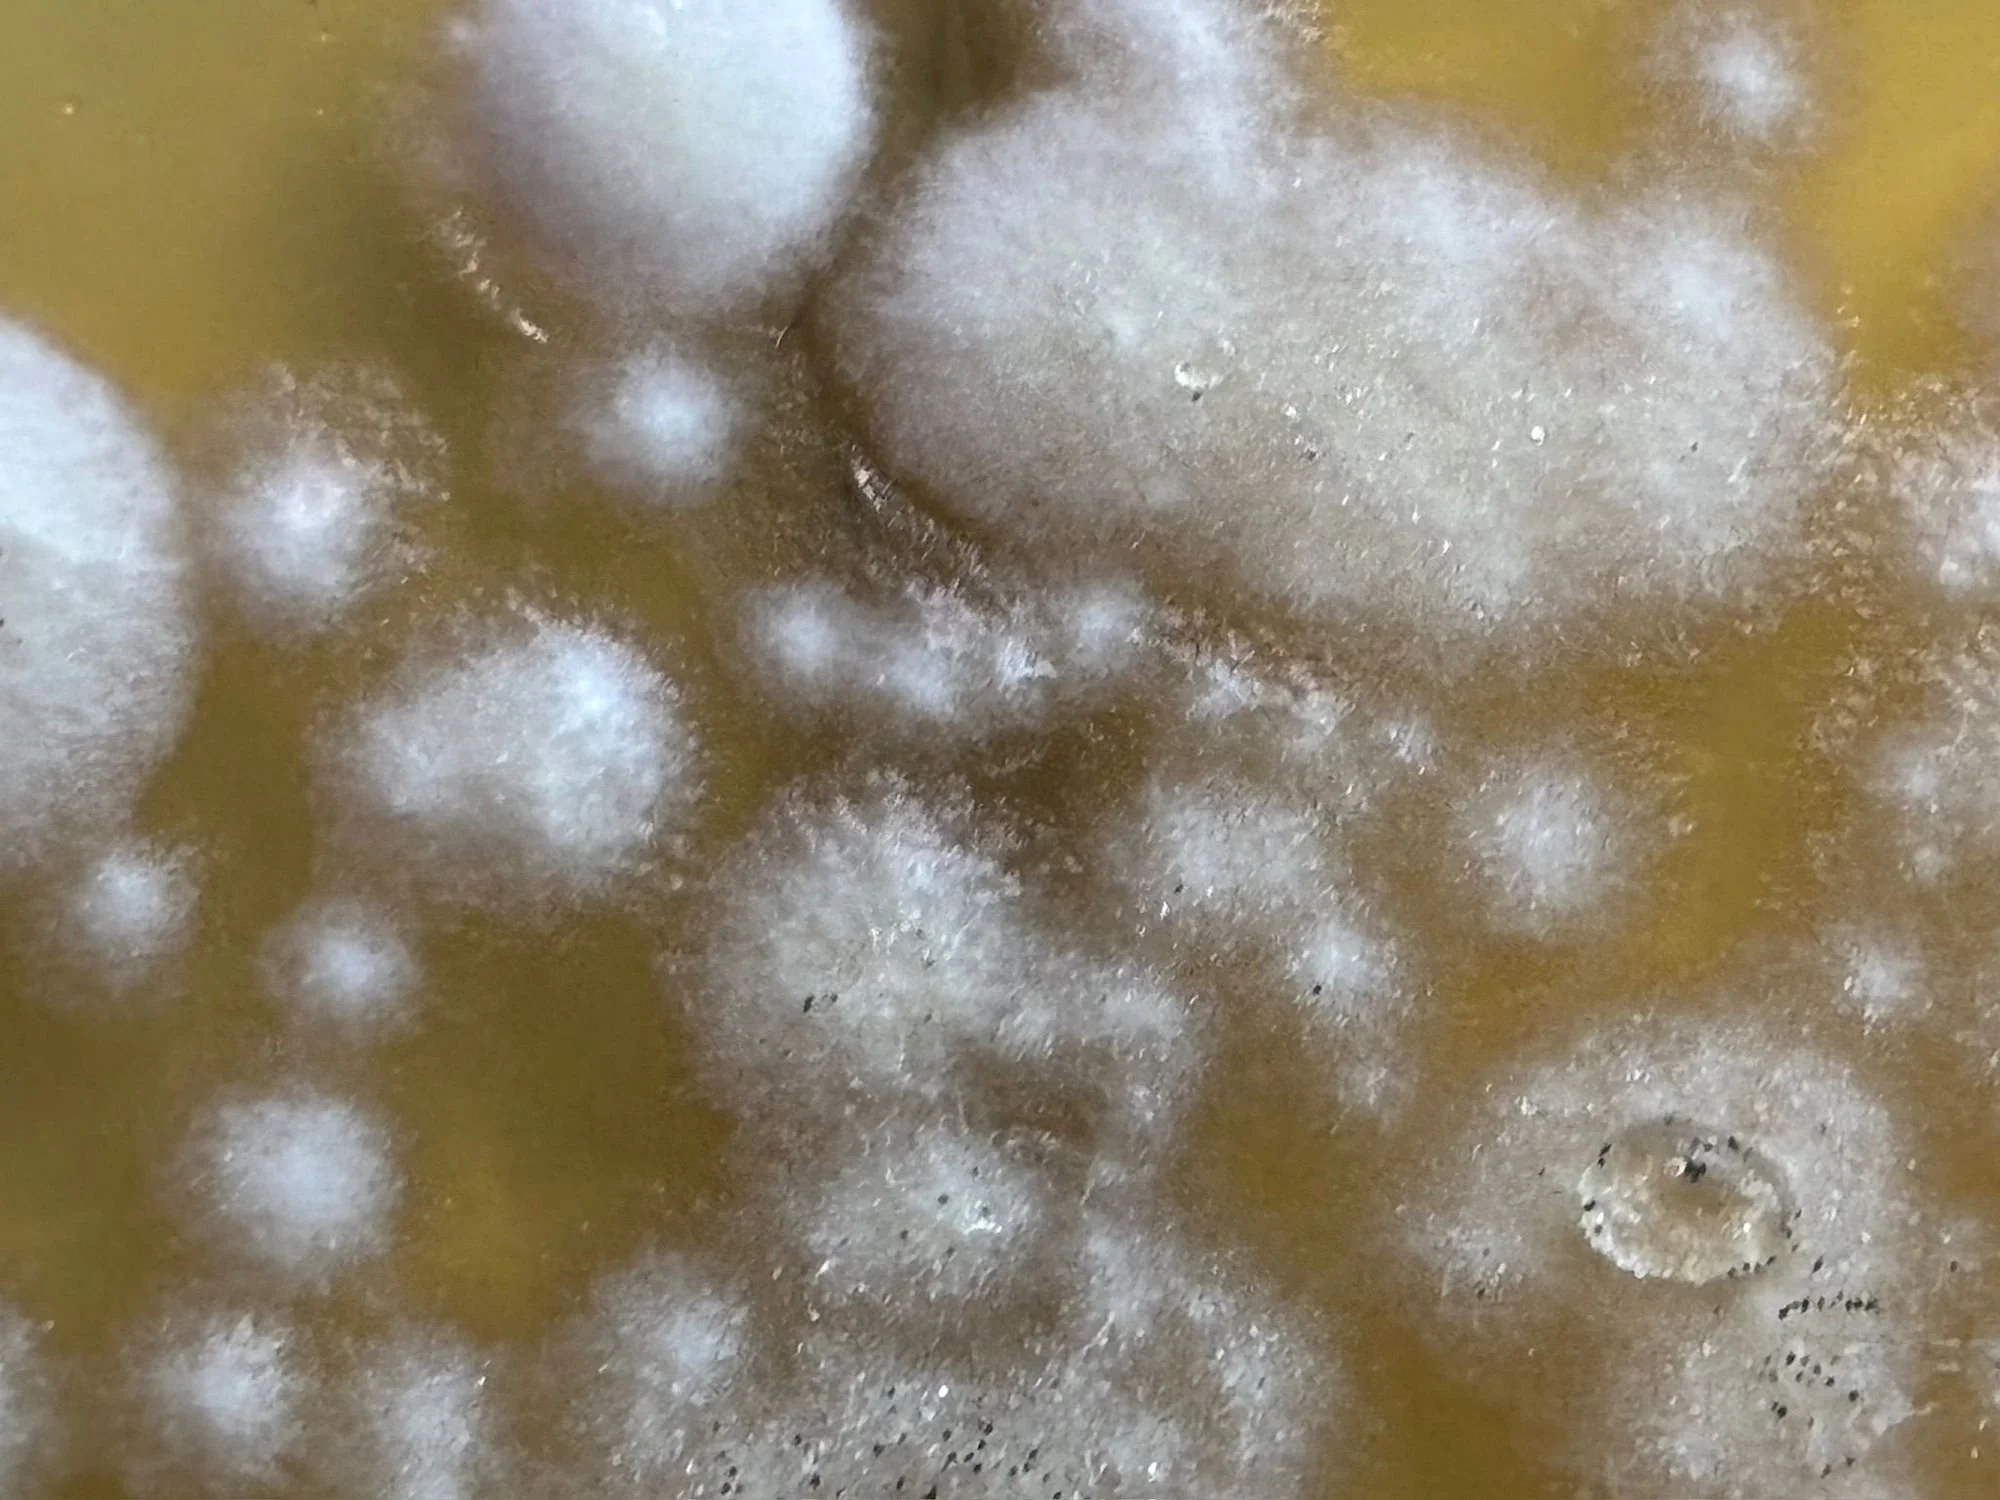

Nel cuore del danno nasce la resilienza, una ricerca tra arte e scienza una nuova vitalità e una narrazione inaspettata
C’è un momento in cui il danno smette di essere solo perdita e diventa osservazione. Dopo aver attraversato il sommerso, ho sentito la necessità di avvicinarmi ancora di più alla materia, di guardarla da vicino, fino a entrare nei suoi processi più nascosti. È così che è iniziata una fase che definisco resilienza visiva, in cui ciò che sembrava degradarsi ha iniziato a rivelare una sorprendente vitalità.
Nel silenzio dello studio, tra carte segnate e superfici compromesse, ho iniziato a notare la presenza di forme organiche invisibili a uno sguardo distratto. Le muffe, comparse sui materiali danneggiati, non erano più un segno di deterioramento, ma una manifestazione di vita. Questo passaggio ha cambiato profondamente il mio modo di intendere il processo creativo.
L’infinitamente piccolo come origine del linguaggio
Osservare le muffe significa entrare in una dimensione altra, dove il tempo si dilata e la materia si trasforma lentamente. Attraverso tamponi, colture e macrofotografia, ho iniziato a indagare queste presenze, lasciando che il rigore dell’osservazione scientifica si intrecciasse con la mia sensibilità visiva.
Quello che emerge da questa indagine è una forma di pittura naturale, in cui il segno non è imposto, ma nasce spontaneamente. Le trame, le espansioni, le variazioni cromatiche raccontano una storia che non appartiene solo all’arte, ma alla vita stessa. È in questo spazio che si genera una nuova ricerca artistica, capace di superare i confini tra discipline.
Guardare da vicino ciò che normalmente verrebbe rimosso è un atto di coraggio. Significa accettare che la bellezza non è sempre immediata, ma può emergere anche da ciò che appare fragile, instabile, in trasformazione.
La gum print: nobilitare la trasformazione
Dall’osservazione nasce il gesto. Le immagini raccolte durante questa fase diventano matrici per la realizzazione di opere attraverso la tecnica gum print, un processo che richiede tempo, precisione e stratificazione.
Utilizzo fotocopie a toner come base, carta Fine Art in cotone e il passaggio sotto torchio per costruire immagini dense, materiche, stratificate. Ogni stampa è il risultato di più cicli: gomma arabica, acqua, inchiostro, pressione. Un processo che richiama, in modo quasi simbolico, l’azione dell’acqua durante l’allagamento.
In questo modo, ciò che nasce da un’osservazione scientifica viene restituito come opera d’arte contemporanea, dove il degrado iniziale viene nobilitato e trasformato in linguaggio. La materia non viene negata, ma esaltata nella sua complessità.
Tra laboratorio e visione
In questa fase, il mio studio si è trasformato in un luogo ibrido, sospeso tra laboratorio e spazio creativo. L’idea di affiancare alle opere elementi come tamponi o colture nasce proprio da questa esigenza: rendere visibile il processo, mostrare che dietro ogni immagine esiste una fase di ricerca e osservazione.
Questa dimensione introduce una riflessione più ampia sul rapporto tra arte e scienza. Non si tratta di sovrapporre linguaggi, ma di farli dialogare, creando un terreno comune in cui la conoscenza diventa esperienza visiva.
Per chi osserva, questo passaggio può rappresentare uno spostamento: non si guarda più solo l’opera finita, ma si entra in relazione con ciò che l’ha generata.
Il valore della resilienza
La resilienza non è una reazione immediata, ma un processo lento. È la capacità di attraversare una trasformazione senza opporsi, lasciando che essa riveli nuove possibilità. In questa fase del mio lavoro ho imparato che la materia non è mai ferma: evolve, si modifica, genera.
Per i collezionisti d’arte e per chi si avvicina a questa ricerca, queste opere rappresentano un momento unico: quello in cui il linguaggio si forma attraverso l’imprevisto, in cui la bellezza nasce da una relazione profonda con il tempo e con la trasformazione.
La resilienza visiva diventa così un ponte tra ciò che è stato e ciò che può ancora emergere.